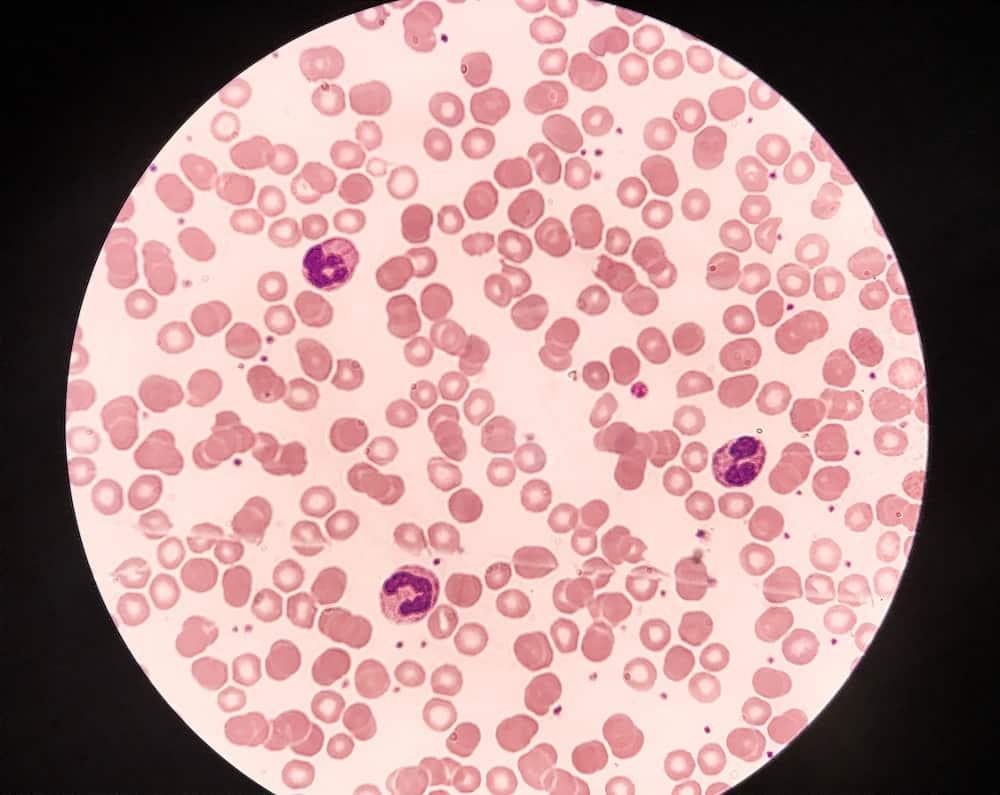
Thiếu máu tán huyết là bệnh gì? Nguyên nhân, triệu chứng và điều trị

Thiếu máu tán huyết không còn là một căn bệnh hiếm gặp. Bệnh cần được quan tâm đúng mực bởi nếu không phát hiện, điều trị sớm, dạng thiếu máu này có thể gây ảnh hưởng tiêu cực đến tất cả các cơ quan trong cơ thể.
Mời bạn cùng Hello Bacsi tìm hiểu cụ thể hơn về căn bệnh này trong bài viết ngay sau đây nhé!
Tìm hiểu chung
Thiếu máu tán huyết là gì?
Thông thường, các tế bào hồng cầu tồn tại khoảng 120 ngày trong cơ thể. Thiếu máu tán huyết (thiếu máu huyết tán hay thiếu máu tan máu) là một rối loạn trong đó các tế bào hồng cầu bị phá hủy sớm hơn bình thường. Sự phá hủy các tế bào hồng cầu được gọi là quá trình tán huyết.
Các tế bào hồng cầu mang oxy đến tất cả các bộ phận của cơ thể. Nếu số lượng hồng cầu thấp hơn bình thường, cơ thể không thể hoạt động tốt được.
Thiếu máu huyết tán có 2 dạng như sau:
- Thiếu máu huyết tán di truyền (hay còn được gọi là thiếu máu tan máu nội sinh) xảy ra do có khiếm khuyết trong chính các tế bào hồng cầu. Đây là kết quả của việc một hoặc nhiều gen kiểm soát việc sản xuất hồng cầu không hoạt động bình thường, khiến hồng cầu bị phân hủy sớm hơn bình thường.
- Thiếu máu huyết tán mắc phải (hay còn gọi là thiếu máu tan máu ngoại sinh) xảy ra do các yếu tố bên ngoài tế bào hồng cầu. Chẳng hạn như rối loạn tự miễn, nhiễm trùng, thuốc… Trong những trường hợp này, tủy xương vẫn sản xuất ra hồng cầu khỏe mạnh. Tuy nhiên, sau đó chúng bị phá hủy trực tiếp trong máu hoặc bị lách giữ lại sớm hơn và phân hủy.
Bệnh thiếu máu huyết tán có nguy hiểm không?
Thiếu máu tan máu nếu không được điều trị kịp thời có thể dẫn đến các biến chứng nguy hiểm, chẳng hạn như nhịp tim không đều hay còn được gọi là loạn nhịp tim, bệnh cơ tim, tim phát triển lớn hơn bình thường, hoặc thậm chí là có thể dẫn đến suy tim.
Triệu chứng
Những dấu hiệu và triệu chứng của bệnh thiếu máu tán huyết

Thiếu máu huyết tán có thể khởi phát đột ngột hoặc từ từ, triệu chứng từ nhẹ hoặc nặng tùy người. Nhìn chung, các triệu chứng của bệnh thiếu máu tán huyết bao gồm:
- Da nhợt nhạt, xanh xao bất thường
- Da, mắt và miệng hơi vàng (vàng da)
- Nước tiểu sẫm màu
- Sốt
- Mệt mỏi
- Chóng mặt (nhiều hơn khi thay đổi tư thế)
- Nhức đầu, lú lẫn, hay quên
- Không thể xử lý các hoạt động thể chất
- Lá lách và gan to
- Nhịp tim nhanh
Thiếu máu tán huyết nghiêm trọng có thể gây ớn lạnh, sốt, đau ở lưng và bụng hoặc sốc.
Các triệu chứng của bệnh này có thể xuất hiện trong nhiều bệnh lý khác. Vì vậy, hãy khám bác sĩ để được chẩn đoán chính xác.
Nguyên nhân
Nguyên nhân gây bệnh thiếu máu tán huyết là gì?
Có 2 dạng thiếu máu huyết tán chính: do di truyền và mắc phải. Nguyên nhân gây ra mỗi dạng bệnh này có thể khác nhau, cụ thể như sau:
Thiếu máu tán huyết di truyền
Nguyên nhân của thiếu máu tán huyết di truyền là do các khiếm khuyết di truyền trong các tế bào hồng cầu, chẳng hạn như:
- Thiếu máu hồng cầu hình liềm
- Bệnh thalassemia
- Rối loạn màng hồng cầu
- Thiếu hụt men pyruvate kinase (PKD)
- Thiếu hụt glucose – 6 – phosphate dehydrogenase (G6PD)
Những tình trạng này tạo ra các tế bào hồng cầu không tồn tại được lâu như các tế bào hồng cầu bình thường.
Thiếu máu tán huyết mắc phải

Với loại thiếu máu này, cơ thể bạn tạo ra các tế bào hồng cầu khỏe mạnh, nhưng sau đó chúng sẽ bị phá hủy nhanh hơn mức bình thường. Nguyên nhân có thể là do:
- Thiếu máu tan máu tự miễn: Do các tình trạng rối loạn tự miễn dịch, chẳng hạn như bệnh lupus, viêm khớp dạng thấp hoặc viêm loét đại tràng, tạo ra các tự kháng thể tấn công hồng cầu và phá hủy chúng.
- Thiếu máu tan máu do thuốc như quinin, quinidin, penicilin, methydopa, ticlopidin, các thuốc chống viêm không steroid NSAID
- Thiếu máu tan máu cơ học do chấn thương trực tiếp, hồng cầu bị phá hủy trong lòng mạch và giải phóng hemoglobin ồ ạt. Hemoglobin này quá nhiều, vượt ra khỏi khả năng tái hấp thu của ống thận nên đi vào nước tiểu, gây tiểu ra huyết sắc tố.
- Cường lách khiến lá lách tăng cường hoạt động tiêu hủy hồng cầu.
- Ung thư máu hay một số khối u, làm giảm hoạt động sản xuất hồng cầu và tạo một số kháng thể làm phá huỷ hồng cầu.
- Van tim cơ học có thể làm hỏng các tế bào hồng cầu khi chúng rời khỏi tim
- Phản ứng nghiêm trọng khi truyền máu
- Sốt rét, rắn độc cắn và các dạng thiếu máu nhiễm trùng khác.
- Nhiễm độc chì, đồng
Một số loại thiếu máu tan máu mắc phải chỉ là tạm thời và có thể biến mất sau vài tháng, nhưng một số loại khác lại là mãn tính và kéo dài suốt đời.
Chẩn đoán và điều trị
Những thông tin được cung cấp không thể thay thế cho lời khuyên của các chuyên viên y tế. Hãy luôn tham khảo ý kiến bác sĩ.
Những kỹ thuật y tế nào giúp chẩn đoán thiếu máu tán huyết?
Bác sĩ sẽ chẩn đoán dựa trên các triệu chứng, hỏi tiền sử bệnh và khám sức khỏe chung. Kế tiếp, bạn bắt buộc cần làm xét nghiệm máu nhằm đánh giá tình trạng của hồng cầu trong máu:
- Công thức máu toàn bộ (CBC): Cho biết tổng số lượng hồng cầu, hemoglobin và hematocrit trong máu
- Các xét nghiệm máu khác. Nếu xét nghiệm CBC cho thấy bạn bị thiếu máu, bạn có thể làm các xét nghiệm máu khác nhằm tìm ra chính xác nguyên nhân và loại thiếu máu tán huyết mà bạn mắc phải cùng mức độ nghiêm trọng của nó. Chẳng hạn như số lượng hồng cầu lưới, số lượng tiểu cầu, điện di protein – huyết thanh, nồng độ Bilirubin trong máu, LDH huyết thanh, nồng độ cacboxyhemoglobin, enzyme pyruvate kinase,…
Ngoài ra, họ cũng có thể yêu cầu bạn tiến hành các xét nghiệm bổ sung sau:
- Xét nghiệm nước tiểu. Để kiểm tra hemoglobin và sắt có trong nước tiểu hay không (dấu hiệu tiểu huyết sắc tố).
- Chọc hút hoặc sinh thiết tủy xương. Bác sĩ sẽ lấy một mẫu nhỏ dịch tủy xương. Sau đó, tiến hành xét nghiệm và kiểm tra số lượng, kích thước và sự trưởng thành của các tế bào máu
- hoặc có các tế bào bất thường trong tuỷ xương hay không.
- Xét nghiệm di truyền phân tích xem có gen bất thường nào tác động vào quá trình tạo máu hay không.
Những phương pháp điều trị thiếu máu tán huyết?
Những người được chẩn đoán mắc bệnh thiếu máu tán huyết nhẹ có thể không cần điều trị. Còn lại, bệnh nhân cần được kiểm soát bệnh, phương pháp tùy theo nguyên nhân gây bệnh cụ thể cũng như mức độ nặng nhẹ. Chẳng hạn như:
- Truyền máu nếu có tình trạng thiếu máu nặng
- Thuốc corticosteroid nhằm chống viêm, ức chế miễn dịch
- Điều trị để tăng cường hệ thống miễn dịch bằng cách sử dụng globulin miễn dịch tiêm tĩnh mạch
- Rituximab điều trị một số loại ung thư.
- Phẫu thuật cắt bỏ lá lách
- Thuốc làm giảm sức mạnh của hệ thống miễn dịch, hạn chế chúng tấn công phá huỷ hồng cầu (liệu pháp ức chế miễn dịch).
Phòng ngừa
Sống chung với bệnh thiếu máu tán huyết
Thảo luận cùng chuyên gia y tế của bạn về các nguy cơ mà hồng cầu có thể bị phá huỷ, nguy cơ nhiễm trùng và tránh chúng. Như là Tthời tiết lạnh có thể kích hoạt sự phân hủy các tế bào hồng cầu. Để bảo vệ bản thân, hãy mặc quần áo ấm, giữ ấm cơ thể.
Ngoài ra, bạn cũng có thể giảm nguy cơ nhiễm trùng bằng cách:
- Tránh xa những người bị bệnh
- Tránh đám đông
- Rửa tay thường xuyên
- Tránh các loại thực phẩm nấu chưa chín
- Đánh răng thường xuyên
- Tiêm phòng cúm mỗi năm.
Hy vọng thông qua bài viết này bạn đã hiểu rõ hơn về căn bệnh thiếu máu tán huyết, cũng như có cách phòng ngừa và điều trị bệnh hiệu quả nhé!